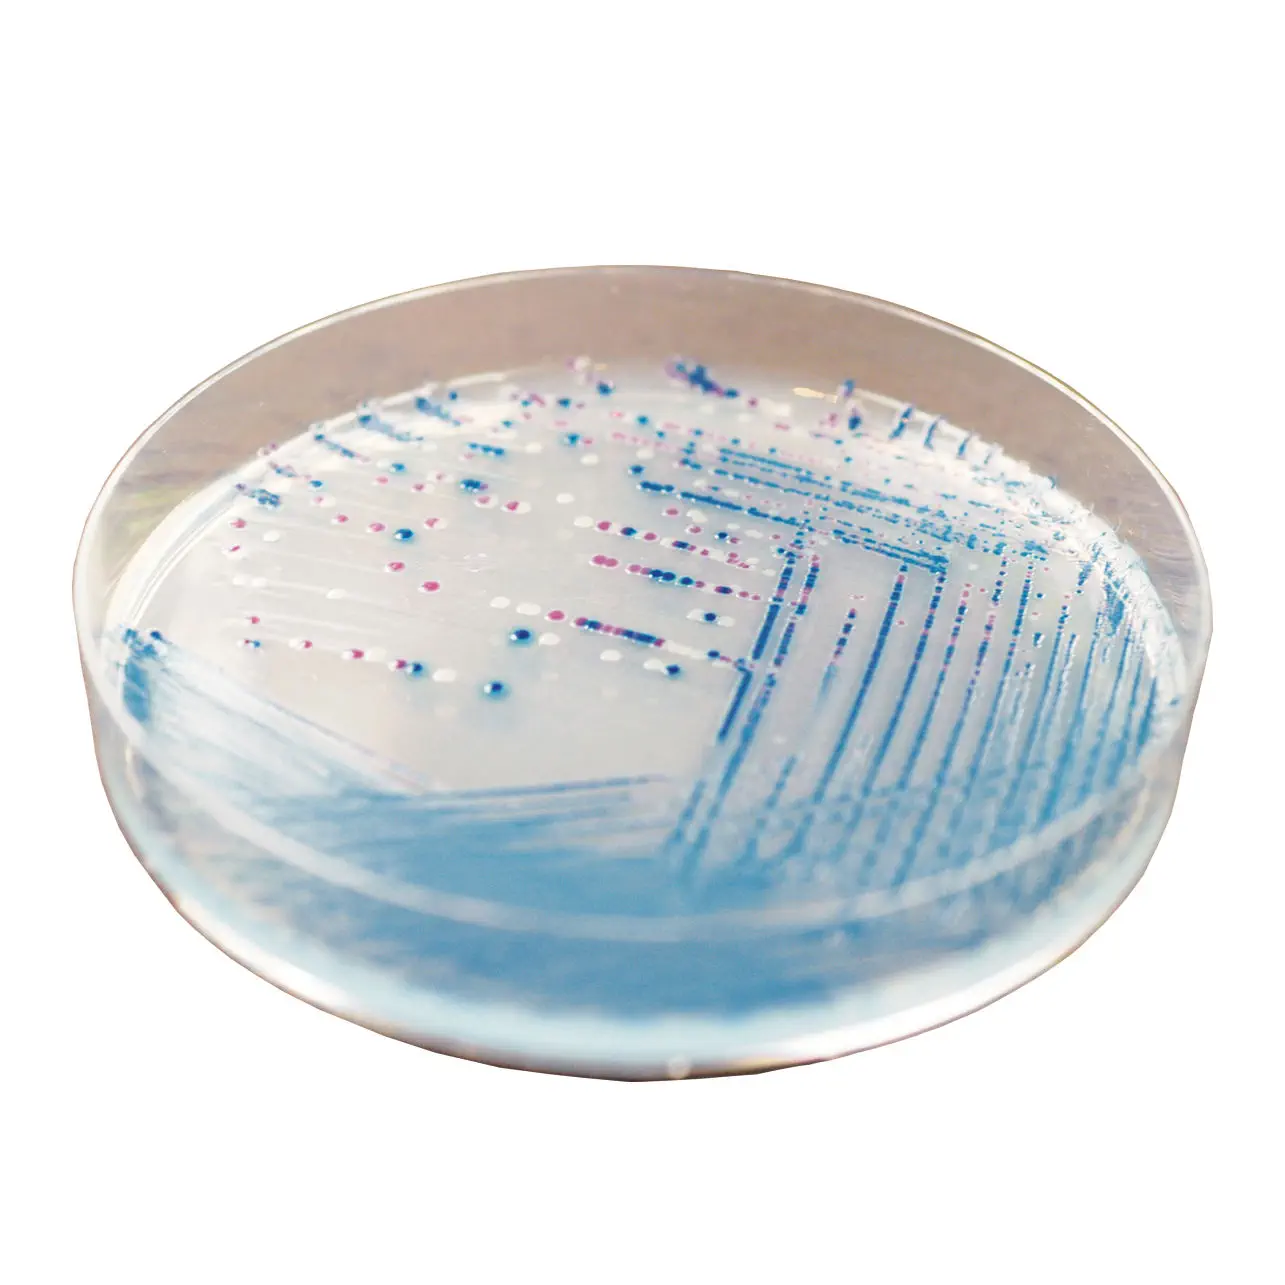

新入荷
再入荷
季節のおすすめ商品 Amazon | 日水製薬 MacConkey寒天培地 顆粒 「ニッスイ タイムセール
 タイムセール
タイムセール
終了まで
00
00
00
999円以上お買上げで送料無料(※)
999円以上お買上げで代引き手数料無料
999円以上お買上げで代引き手数料無料
通販と店舗では販売価格や税表示が異なる場合がございます。また店頭ではすでに品切れの場合もございます。予めご了承ください。
商品詳細情報
| 管理番号 |
新品 :3752036165
中古 :3752036165-1 |
メーカー | 3ae7741d | 発売日 | 2025-04-06 21:48 | 定価 | 6600円 | ||
|---|---|---|---|---|---|---|---|---|---|
| カテゴリ | |||||||||

![エスコ [EA898RF-42用] 替刃 EA898RF-46](https://m.media-amazon.com/images/I/217SKPmhfoL.jpg)


![[スリーエム] 3M バーサフロー[[TM上]] ロングバッテリー TR-332 7010603069](https://m.media-amazon.com/images/I/21e39Ss8a3L.jpg)
















